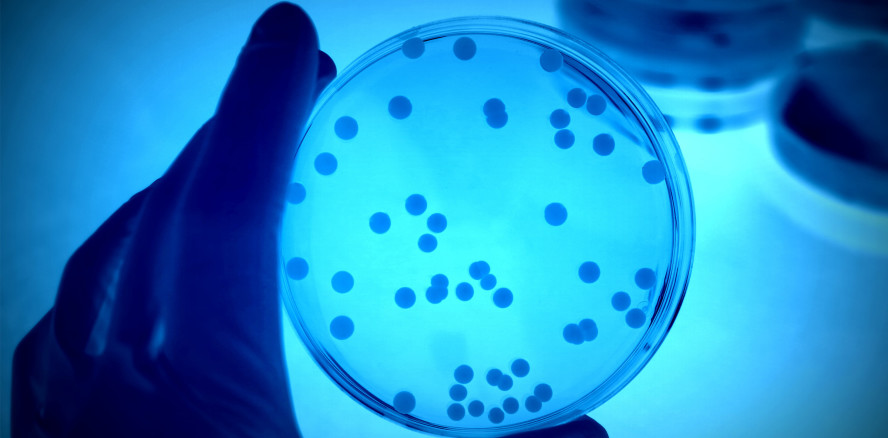
Mikrobiologische Grundlagen der PA-Therapie

Prophylaxe 22.03.2019
Mikrobiologische Grundlagen der PA-Therapie
share
Zurück zur Symbiose
Parodontalerkrankungen basieren neuesten Untersuchungen zufolge auf einem gestörten Gleichgewicht der subgingivalen Bakteriengemeinschaft. Mikrobiologische Testverfahren können eine solche Dysbiose über die Analyse von Indikatorkeimen aufdecken und machen eine personalisierte, diagnostisch abgesicherte Behandlung möglich.
In den Koch’schen Postulaten ist definiert, dass Infektionserkrankungen durch einen spezifischen, meist exogenen Erreger ausgelöst werden. Die Parodontitis ist zwar ebenfalls eine bakterielle Infektionserkrankung, stellt diesbezüglich aber eine Ausnahme dar. Sie wird nämlich nicht nur durch einen einzelnen Keim, sondern durch eine Gruppe verschiedener Bakterienspezies ausgelöst und vorangetrieben. Diese Erreger, die in ihrer Zusammensetzung und Konzentration von Patient zu Patient erheblich variieren können, werden als parodontopathogene Bakterien zusammengefasst.22,26 Dabei ist es wichtig zu wissen, dass es sich bei der Parodontitis um eine sogenannte opportunistische Erkrankung handelt. Das bedeutet, dass die parodontitisverursachenden Bakterien zwar auch beim parodontal Gesunden vorhanden sind, aber meist erst dann zum Problem werden, wenn sie sich ausbreiten und vermehren können.15,16,26 Entscheidende Faktoren, die zum Ausbruch der Erkrankung beitragen können, sind z. B. eine unzureichende Mundhygiene oder Rauchen, aber auch Stress und verschiedene Allgemeinerkrankungen können das Entstehen einer Parodontitis fördern.17
Grundsätzlich wird das gesunde Parodont von grampositiven, aeroben Bakterienspezies dominiert. Diese gesundheitsassoziierten Keime stellen eine Bakteriengemeinschaft dar, die im gesunden Zustand in einem harmonischen Gleichgewicht miteinander und mit dem Wirt existiert, sie bilden also eine Symbiose. Man bezeichnet diese Gruppe von Bakterien auch als benefizielle Flora, da sie bei der Aufrechterhaltung des oralen Milieus eine wichtige Rolle spielen.5,14–16 Dementgegen kommen parodontopathogene Spezies zwar auch im gesunden Sulkus vor, machen hier aber nur einen geringen Anteil der Bakteriengemeinschaft aus. Im Idealfall wird ihre Anzahl sowohl vom Immunsystem des Wirts, als auch durch die benefiziellen Bakterien unter Kontrolle gehalten.2,5,13–16,25 Ändern sich allerdings die Standortfaktoren, wandelt sich nachfolgend auch die Zusammensetzung der Bakteriengemeinschaft. Es setzen sich jene Bakterienspezies durch, die den veränderten Bedingungen am besten angepasst sind (Abb. 1).15,16
Die Vorgänge am Zahnfleischsaum
Wenn sich Plaque aufgrund ineffizienter Mundhygiene am Zahnfleischsaum ansammelt, wird dort eine lokale Entzündungsreaktion ausgelöst. Diese bewirkt einerseits eine Erhöhung der Sulkusflussrate und somit auch des Nährstoffangebots, andererseits führt sie aber auch zu einem Absinken der Sauerstoffkonzentration im Sulkus. Insgesamt betrachtet, begünstigen diese entzündlichen Veränderungen das Wachstum der parodontopathogenen Bakterien, da diese anaerob bzw. fakultativ anaerob sind und deshalb Standorte mit möglichst geringer Sauerstoffkonzentration bevorzugen. Für die benefiziellen Bakterien des gesunden Parodonts sind diese Veränderungen hingegen weniger vorteilhaft und ihr prozentualer Anteil an der Subgingivalflora geht deutlich zurück.5,14–16
Die parodontopathogenen Bakterien lösen ihrerseits eine Immunreaktion des Körpers aus und produzieren verschiedene Zellgifte, was schließlich zu einer fortschreitenden Zerstörung des Zahnhalteapparats und zunehmend tiefen Zahnfleischtaschen führt.2 So werden die Bedingungen für das Wachstum anaerober Bakterien immer besser und es entsteht ein Teufelskreis, in dem sich die Parodontitis manifestiert. Zu diesem Zeitpunkt ist die orale Mikroflora aus dem Gleichgewicht geraten und aus der Symbiose hat sich eine Dysbiose entwickelt.14,16 Aber nicht nur das: Auch die Gesamtmenge der Bakterien im Sulkus ist während der Entwicklung einer Parodontitis rasant angestiegen. Um etwa drei Log-Stufen nimmt die Bakterienmenge im parodontal erkrankten Sulkus im Vergleich zu gesunden Verhältnissen zu.1,2,5 Diese Zunahme wird dabei in erster Linie durch die Vermehrung parodontopathogener Bakterien getragen.
Indikatorkeime zeigen Dysbiose an
Die Grundlage unseres heutigen Wissens über die Ursachen der Parodontitis stellen die Arbeiten von Socransky und Haffajee zur Mikrobiologie von Parodontalerkrankungen dar.24,25 Die Wissenschaftler der Harvard University in Boston konnten bereits vor 20 Jahren zeigen, dass sich Zusammensetzung und Konzentration der verschiedenen Bakteriengruppen als Reaktion auf die veränderten Standortfaktoren ändern. In ihrer „Komplextheorie“ ordnen sie die beteiligten Bakterienspezies gemäß ihrer Pathogenität und Rolle im Verlauf der Parodontitisentwicklung unterschiedlichen Komplexen zu (Abb. 2). Es sind vor allem die Bakterien des roten Komplexes und Aggregatibacter actinomycetemcomitans, die durch die Produktion verschiedener Enzyme und Zellgifte die Hauptverantwortung für die Zerstörung des Zahnhalteapparats tragen.3,4,8 Darüber hinaus besitzen diese Bakterien die Fähigkeit, in die Zellen des Parodontalgewebes einzudringen und können deshalb durch eine rein mechanische Reinigung nicht effizient entfernt werden. Eine Reduktion dieser Keime ist häufig nur durch eine antibiotische Begleittherapie, die auch die im Gewebe lokalisierten Bakterien erfasst, möglich.3,9,13,18,22–24 Vor diesem Hintergrund muss die Analyse dieser parodontopathogenen Bakterienspezies nach wie vor als die Methode der Wahl zur mikrobiologischen Diagnostik im Rahmen der Parodontitistherapie gelten. Schließlich lassen sich durch den Nachweis dieser Indikatorkeime und deren Konzentration Rückschlüsse auf das Ausmaß der Dysbiose und damit den Fortschritt der Erkrankung ziehen. Gleichzeitig lassen sich dadurch fundierte Entscheidungen über die Notwendigkeit einer begleitenden Antibiose und die optimale Wirkstoffauswahl treffen, zumal sich das subgingivale Keimspektrum von Patient zu Patient deutlich unterscheiden kann.26
PA-Therapie: Atombombe oder gezielte Wiederherstellung?
Die Hauptziele einer erfolgreichen Parodontitistherapie sind in erster Linie die Beseitigung der Entzündung und die Wiederherstellung gesunder mikrobiologischer Verhältnisse. Dabei sollten auch die äußeren Faktoren möglichst derart verbessert werden, dass sie die Regenerierung einer gesunden symbiontischen Bakteriengemeinschaft unterstützen. So ist neben einer Verbesserung der häuslichen Pflegemaßnahmen und der Herstellung optimaler Hygienefähigkeit, die Entfernung des Biofilms durch eine sorgfältige mechanische Reinigung der Wurzeloberflächen im Sinne einer „Full Mouth Disinfection“ die wichtigste Maßnahme zur Reduktion der Bakterienbelastung.12,19–21
Insbesondere beim Vorliegen gewebeinvasiver parodontopathogener Bakterien kann parallel dazu der unterstützende Einsatz eines systemischen Antibiotikums notwendig sein, um die verantwortlichen Bakterien nachhaltig zu reduzieren und die parodontale Situation langfristig zu stabilisieren.7,10,11,18,20 Dabei sollten möglichst solche Antibiotika verwendet werden, die ein schmales Wirkspektrum haben und gezielt gegen die jeweils individuell vorliegenden Parodontitisbakterien gerichtet sind. Im Idealfall werden so die im Zuge der Parodontitisentstehung zurückgedrängten, benefiziellen Bakterienspezies während der antiinfektiösen Therapie geschont und können nach erfolgter Reduktion der PA-Keime den Sulkus wieder neu besiedeln.5,14–16 Diesen wichtigen mikrobiologischen Aspekt berücksichtigt der unreflektierte Einsatz der Antibiotikakombination aus Amoxicillin und Metronidazol (sog. „Winkelhoff-Cocktail“) nicht. So zeigen verschiedene wissenschaftliche Untersuchungen4,5, dass gerade die mit parodontaler Gesundheit assoziierten Bakterienspezies empfindlich gegenüber Amoxicillin sind. Eine statistische Auswertung von ca. 170.000 Patientenproben (micro-IDent®, Hain Lifescience GmbH) offenbart darüber hinaus, dass bei ca. 75 Prozent der Parodontitispatienten eine Kombinationstherapie mit dem Winkelhoff-Cocktail nicht zwingend notwendig ist (Abb. 3).
So wäre ein Großteil dieser Patienten (68,59 Prozent) z. B. durch eine adjunktive Behandlung mit Metronidazol alleine ausreichend versorgt.6 Wird der Winkelhoff-Cocktail also lediglich aufgrund eines schlechten klinischen Bildes eingesetzt, ohne das Bakterienspektrum vorher abzuklären, stellt dies häufig eine Übertherapie dar, bei der die benefizielle Flora unnötigerweise abgetötet wird.
Molekularbiologische Diagnostik
Mithilfe von Markerkeimanalysen (z. B. micro-IDent® und micro-IDent®plus, Hain Lifescience GmbH; Abb. 4) ist eine gezielte Behandlungsplanung möglich, die sich konkret auf die mikrobiologische Situation des jeweiligen Patienten bezieht. So lassen sich nicht nur die parodontopathogenen Bakterienspezies nachweisen, sondern auch deren Konzentrationen bestimmen. Liegen die parodontitisassoziierten Keime in erhöhter Konzentration vor, so lässt dies in Kombination mit dem klinischen Bild Rückschlüsse auf den Grad der im Sulkus vorliegenden Dysbiose zu. Auf Grundlage des Testergebnisses kann man entscheiden, ob eine spezifische, auf den Patienten abgestimmte antibiotische Unterstützung der mechanischen Parodontitistherapie notwendig ist, und wenn ja, welche (Abb. 5).20,26 So kann durch die Kenntnis des individuellen Keimspektrums eine erregerbasierte Wirkstoffauswahl nach dem Prinzip „so viel wie nötig und so wenig wie möglich“ getroffen werden. Darauf basierend kann dann eine gezielte Reduktion der parodontopathogenen Erreger erfolgen, ohne die benefiziellen Bakterienspezies dabei mehr als erforderlich zu schädigen. Nur diese Vorgehensweise fördert die Wiederherstellung einer gesunden, symbiontischen Bakteriengemeinschaft optimal.
Fazit
Die parodontale Gesundheit wird maßgeblich vom Grad der mikrobiologischen Symbiose bestimmt. Gerät diese aus dem Gleichgewicht, dominieren parodontopathogene Bakterien die orale Bakteriengemeinschaft. Sie treiben das Entzündungsgeschehen und die Zerstörung des Zahnhalteapparats ständig weiter voran. Um die symbiontischen Verhältnisse wiederherzustellen, müssen einerseits die Parodontitisbakterien gezielt reduziert und andererseits die benefiziellen Bakterien möglichst geschont werden. Ist im Rahmen der Parodontitistherapie eine unterstützende Antibiotikabehandlung notwendig, ermöglichen mikrobiologische Analysen des subgingivalen Keimspektrums eine zielgerichtete Behandlung. So kann die im Verlauf der Erkrankung entstandene Dysbiose optimal bekämpft und ein gesundes, symbiontisches Gleichgewicht wiederhergestellt werden.
Die vollständige Literaturliste gibt es hier.
Der Beitrag ist im Prophylaxe Journal erschienen.